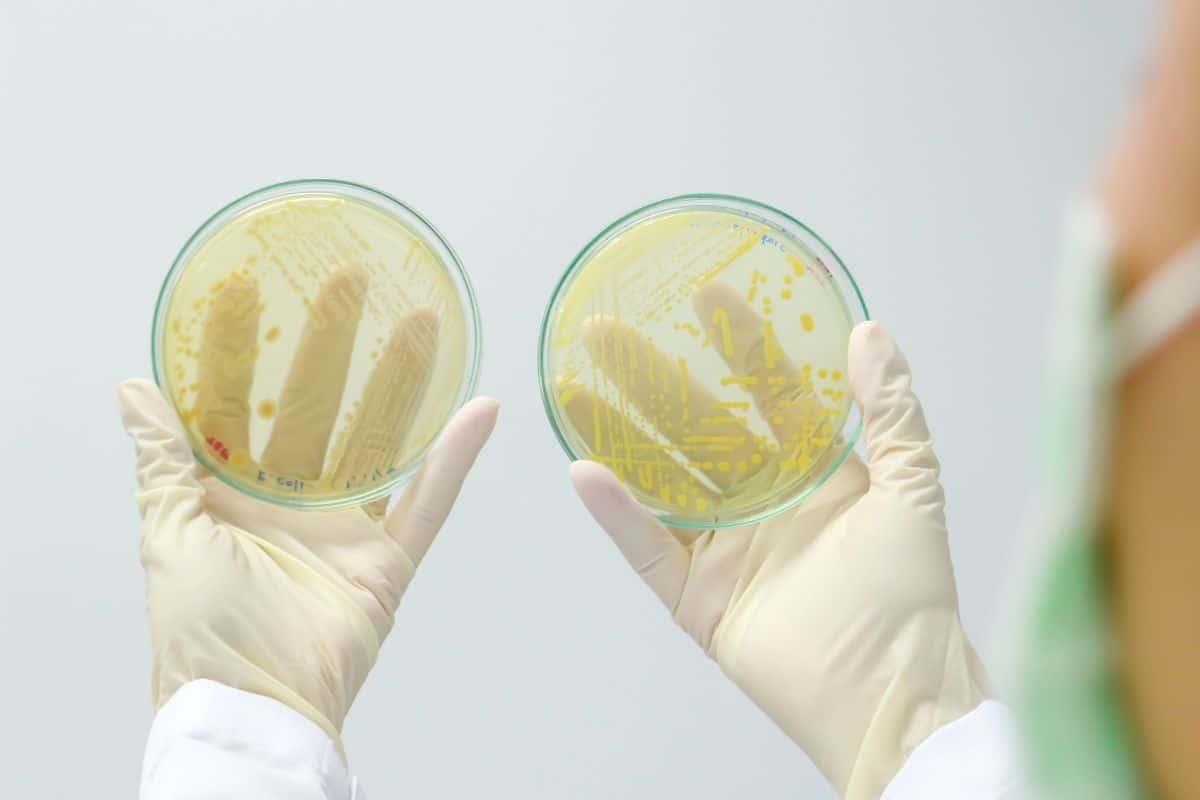
Bactérias resistentes a antibióticos se proliferam nos hospitais

janeiro 15, 2024
Veolia Water Technologies: Soluções Móveis de Tratamento e Reúso de Água para Enfrentar Desafios Emergentes na Escassez de Recursos Hídricos.
Bracell Recebe Selo Prata do EcoVadis em Reconhecimento às Práticas Sustentáveis em 2023.
Estima-se que, a cada ano, no mundo, ocorram cerca de 136 milhões de casos de infecção hospitalar causados por esses micro- organismos.